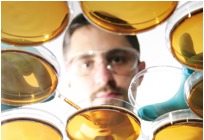
Lancement du 2ème appel à projets de recherche & développement

Le pôle d’innovation Tahiti Fa’ahotu
Créé en août 2009, et reconnu « grappes d’entreprises » en mai 2010, le pôle d’innovation Tahiti Fa’ahotu regroupe des entreprises polynésiennes et des organismes de recherche et de formation locaux, autour d’un objectif commun :
L’innovation pour la valorisation des ressources naturelles de Polynésie.
Tahiti Fa’ahotu regroupe à ce jour 32 entreprises et 6 organismes de recherche et de formation. Le pôle développe des projets et des actions autour de quatre thématiques :
- la valorisation des ressources naturelles marines,
- La valorisation des ressources naturelles terrestres,
- La biodiversité, les biotechnologies et les molécules d’intérêt,
- Les énergies renouvelables et la préservation durable des milieux.
Le pôle d’innovation Tahiti Fa’ahotu développe des actions telles que :
· L’organisation de conférences, permettant de stimuler les échanges entre les entreprises et les chercheurs (conférence sur les cocotiers de Polynésie, un prix spécifique aux Doctoriales 2011…) ;
· Le développement de partenariats avec d’autres pôles, permettant le désenclavement et le rayonnement de la Polynésie : convention passée avec les pôles de compétitivité Mer Bretagne et Mer Paca,
· L’appui des entreprises dans le montage de projets de recherche et développement.
Tahiti Fa’ahotu a ainsi lancé en juin 2010 un premier appel à projets de recherche et développement, en partenariat avec les gestionnaires du volet recherche contrat de projets état – Polynésie.
3 projets labellisés au premier appel à projets de juin 2010
Le premier appel à projets a été un succès, puisque 10 projets ont été déposés :
- 2 projets relevant de la thématique 1 : exploitation des ressources naturelles marines ;
- 6 projets relevant de la thématique 2 : exploitation des ressources naturelles terrestres ;
- 2 projets relevant de la thématique 3 : biodiversité, biomolécules d’intérêt et biotechnologies.
9 projets ont été déclaré éligibles et soumis à des expertises scientifiques et technico-économiques indépendantes. A l’issue du processus d’expertise, 3 projets ont ainsi été labellisés par le pôle.
| nom | thème | porteur | partenaire scientifique | budget total |
| HAARI | étude de la diversité variétale du cocotier en Polynésie dans la perspective de transformations et de valorisations alimentaires | Manutea | Criobe | 14.930.000 XPF |
| ProPHA | criblage de bactéries productrices de bioplastiques | Pacific Biotech | Criobe | 16.000.000 XPF |
| CIGUATRAIT | Etude et valorisation industrielle d’un remède traditionnel à application thérapeutique dans le traitement des intoxications ciguatériques. | Pacific Biotech | IRD | 22.600.000 XPF |
Les 3 projets labellisés ont obtenu un financement par le volet recherche du contrat de projets état – Polynésie.
Lancement du deuxième appel à projets de recherche & développement
Cet appel à projets est à destination des entreprises polynésiennes, souhaitant mener des travaux de recherche pouvant déboucher sur un développement économique. Tout ou partie des travaux de recherche seront effectués par un laboratoire public de recherche.
Le programme de recherche & développement doit être d’une durée maximum de 24 mois.
La clôture de l’appel à projets est fixée au vendredi 19 août 2011.
Les projets déposés seront expertisés de façon indépendante. Les projets expertisés favorablement seront labellisés par le pôle d’innovation Tahiti Fa’ahotu, puis présentés pour financement aux autorités du « Contrat de projet Etat-Pays 2008-2013 ».
Le taux maximum d’aides est fixé à 80% des coûts éligibles du projet, l’aide étant plafonnée à 4.800.000 xpf.
Les entreprises candidates sont invitées à déposer leur dossier par mail ([email protected] ) et/ou sur CD-Rom au pôle d’innovation Tahiti Fa’ahotu.
Le dossier doit obligatoirement être rédigé sur les documents-type téléchargeables sur www.tahitifaahotu.pf :
- faahotu_dossier_projet_mai2011.doc
- faahotu_depenses_projet_mai2011.xls
Contacts pour tous renseignements :
Hélène Gueguen – Tahiti Fa’ahotu – 28.67.65
Daniel Radford – CCISM – 47.27.28































